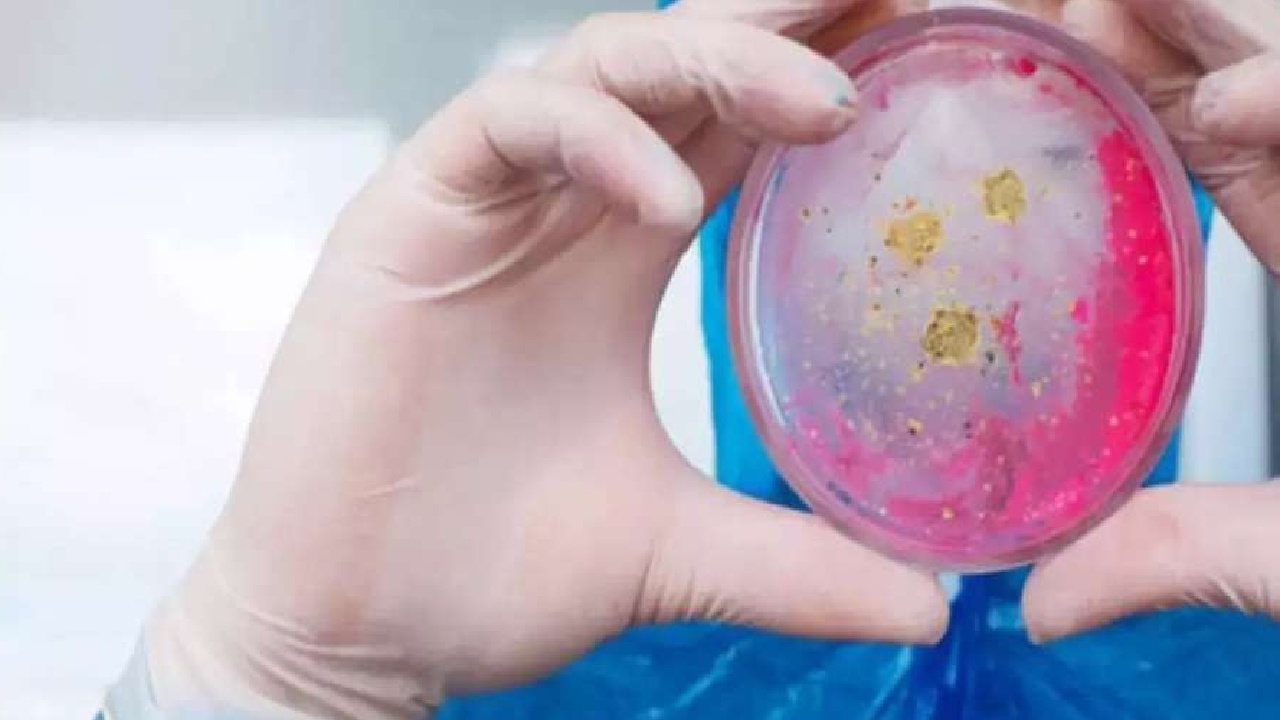

लसुन नेपालीको भान्सामा नभई नहुने मसला हो। लसुनले खाना स्वादिलो पार्नुकासाथै अन्य धेरै फाइदाहरु छन्। अझ अङ्कुरित लसुन स्वास्थ्यका लागि अति फाइदाजनक मानिन्छ।
बिज्ञापन
सामान्य रूपले नियमित लसुन सेवनले मुटुको रोग, कोलेस्ट्रोल, उच्च रक्तचाप, क्यान्सर, विभिन्न सङ्क्रमण आदि रोगबाट जोगिन सघाउँछ। एउटा अध्ययन अनुसार लसुनको दाँजोमा अङ्कुरित लसुनले विभिन्न रोगसँग लड्न बढी सघाउँछ।
बिज्ञापन
-लसुन खानुका फाइदाहरु:
१-क्यान्सर:
बिज्ञापन

अङ्कुरित लसुनमा फाइटो केमिकल हुन्छ। जसले शरीरमा क्यान्सरको सेल्स बढ्नबाट रोक्छ र क्यान्सरको खतराबाट टाढा राख्न मद्दत गर्छ।
२-स्वस्थ मुटु:

अङ्कुरित लसुनमा एन्टिअक्सिडेन्ट तत्व प्रशस्त मात्रामा हुन्छ। जसले मुटुलाई स्वस्थ राख्नमा मद्दत गर्छ।
३-स्ट्रोक:

अङ्कुरित लसुनमा एंन्जोन प्रशस्त मात्रामा हुन्छ। जसले शरीरमा रगत जम्नबाट रोक्छ। र स्ट्रोकको खतराबाट मुक्ति मिल्छ।
४-सुन्दर त्वचा :

अङ्कुरित लसुनको सेवनले त्वचालाई सुन्दर बनाउनुका साथै चाउरीपनाबाट रोक्छ।
५-रोगप्रतिरोध क्षमता:

अङ्कुरित लसुनमा प्रशस्त मात्रामा एन्टिअक्सिडेन्ट तत्व पाइने भएकोले यसको सेवनले शरीरमा रोगसंग लड्न सक्ने क्षमताको बृद्धि गर्न मद्दत गर्छ ।
६-ब्याक्टेरियाबाट बचाउँछ:
अङ्कुरित लसुनको सेवनले भाइरल इन्फेक्सन तथा ब्याक्टेरियाबाट बचाउँछ।
७-ब्लडप्रेशर:

यसको सेवनले शरीरमा कोलेस्ट्रोलको मात्रा नियन्त्रण गर्नुका साथै ब्लडप्रेशर सम्बन्धी समस्याबाट टाढा राख्छ।
८-पाचनशक्ति:

अङ्कुरित लसुनको नियमित सेवन गर्नाले शरीरमा पाचनशक्ति बढाउँछ र खाना पचाउन मद्दत गर्छ। साथै यसले ग्यास्ट्रिक हुन बाट पनि बचाउँछ।
९-कब्जियत:

अङ्कुरित लसुनको नियमित सेवनले कब्जियत जस्ता समस्या निको हुन्छ।
-यो पनि पढ्नुहोस्:
के तपाईं दैनिक लिपस्टिकको प्रयोग गर्नुहुन्छ? जान्नुहोस् यसबाट हुने नोक्सानी!










































